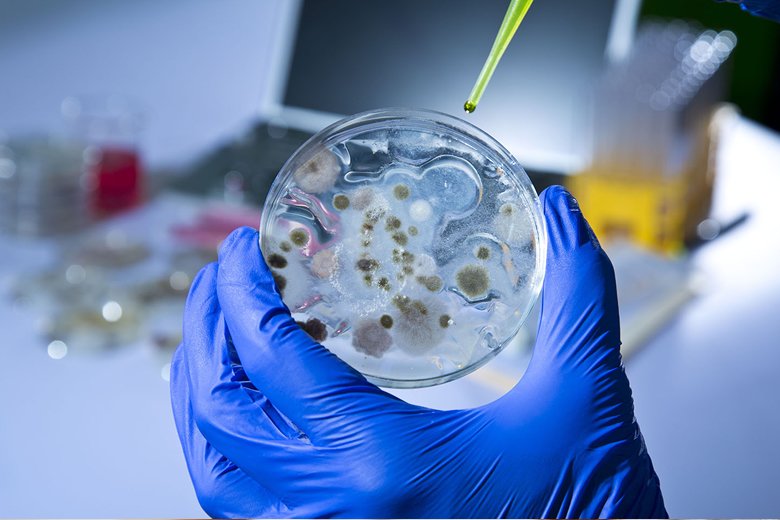
Service Image

Microbial Analysis of water
The most effective way to check water supplies for faecal contamination is microbiological analysis, and a range of test methods designed for that purpose has been developed for the water industry. Instead of carrying out separate tests for each of the potential pathogens, viruses, or parasites that might be in the water, microbiologists test for indicator organisms that are always present when enteric pathogens and viruses.
Contaminated water is globally the main vehicle for microbial pathogens in most regions. Teaching future microbiologist and employees in the food industry on the importance of hygienically satisfactory water, microbiological analyses and how to ensure good water quality and safety is highly relevant. This paper presents a complete experimental design for water analyses as a tool to teach students the methods and other key elements in microbiology, including food safety, environmental dissemination and survival of microorganisms, laboratory practices, water legislation and critical evaluation of results.